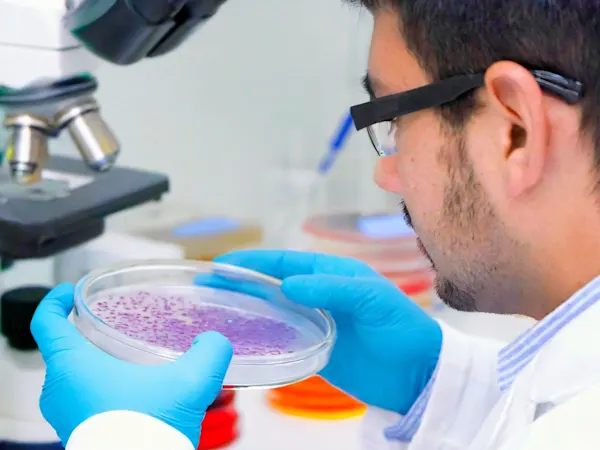
Scientist doing culture work
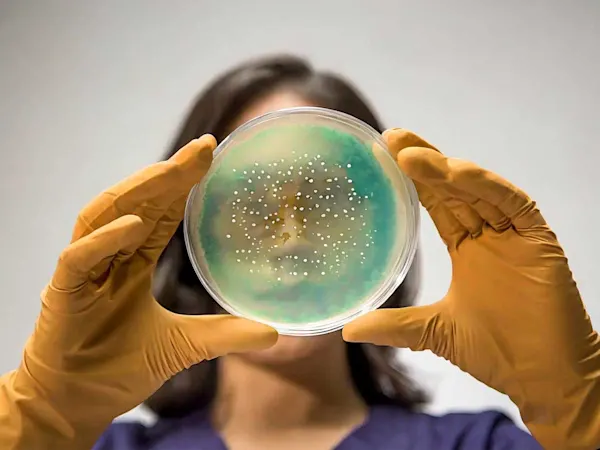
Woman holding up a petri dish and examining it

EPA Takes Action to Gather Data on MBOCA Under TSCA
This marks the first use of the EPA's section 8(c) authority in over 30 years, signalling a robust approach to chemical risk evaluation.
Search and browse our complete archive of chemical regulatory news.
Showing 16 articles on page 41 of 41

This marks the first use of the EPA's section 8(c) authority in over 30 years, signalling a robust approach to chemical risk evaluation.

The latest draft presents a significant update, featuring 28 substances, including 11 new entries compared to the plan for 2023-2025.
A key consequence of this amendment is the removal of the 'Wipe 4 2L (105 wipes)' from the Union authorisation.

Cadmium is used in quantum dots for LED applications due to its unique electronic and optical properties.

Without this rule, companies could have resumed uses of these PFAS absent notification to and review by EPA.

These opinions are a significant step in the ongoing scientific and technical evaluation of chemicals under the GB CLP Regulation.

These address physicochemical properties, in vitro testing for immunotoxicity and skin sensitisation, and enhanced ecotoxicity assessments.

The illegal items include electrical devices, sports equipment, children's toys and fashion products.

The granted exemption will expire on 28 May 2028, which coincides with a scheduled review of related restrictions under REACH.

Learn how the updated PRIO database aids in eliminating PFAS from products. Stay informed and proactive.

This marks a pivotal shift in the battle against disease-spreading mosquitoes, particularly the invasive Asian Tiger Mosquito.

Uses include functional chrome plating of engine valves and valve actuation (‘lash adjusters’).

Consultations on harmonised classification and labelling, new intentions and proposals to harmonise classification and labelling.

The Commission's approval comes with specific provisions on use to ensure environmental and worker safety.

The program seeks to encourage the creation and registration of novel insecticides targeting these resistant mosquito populations.
The contract is crucial for the development of NAM-based tools and data for the hazard identification and characterization chemicals.
Subscribe to Foresight Weekly and get the latest insights on regulatory changes affecting chemical compliance.
Free forever. Unsubscribe anytime.
Read by professionals at